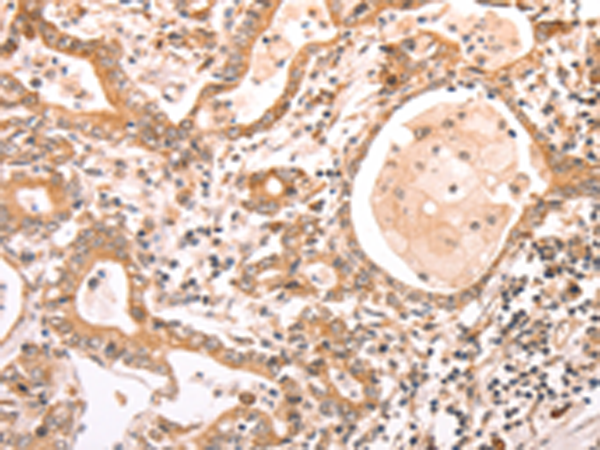
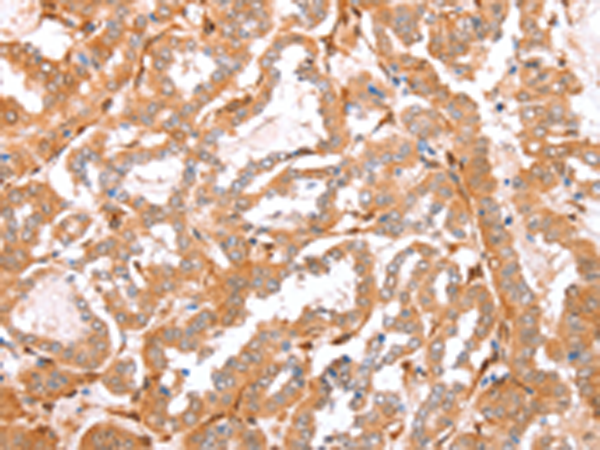
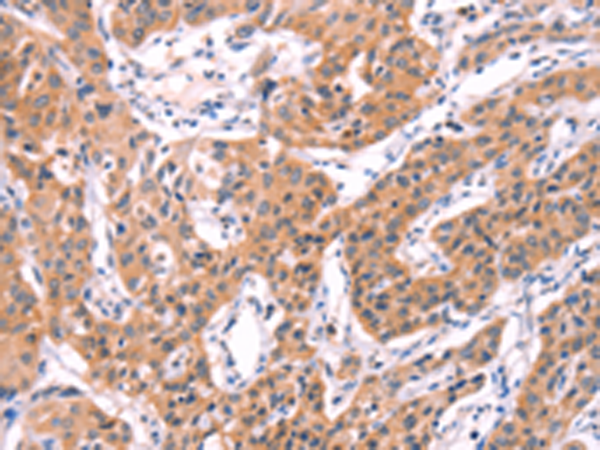
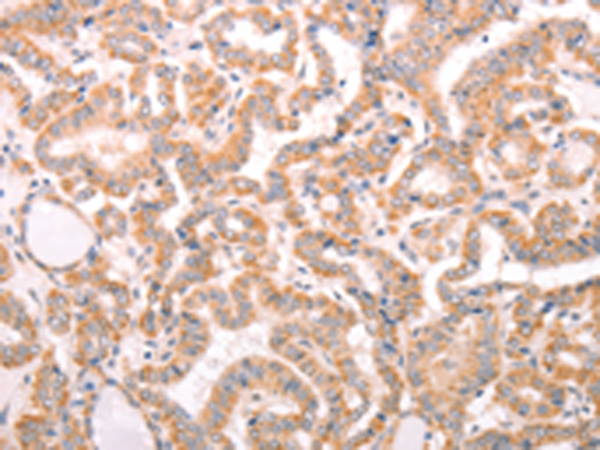

-
分类: 科研抗体货号: P07717别名: ME1; PCDH3X; PCDHB8a; PCDH-BETA16应用: IHC反应种属: Human
-
分类: 科研抗体货号: P07733别名: WHITE2应用: WB反应种属: Human, Mouse
-
分类: 科研抗体货号: P07748别名:应用: IHC反应种属: Human, Mouse
-
分类: 科研抗体货号: P07716别名: T1; ST2; DER4; ST2L; ST2V; FIT-1; IL33R应用: WB,IHC反应种属: Human
-
分类: 科研抗体货号: P07732别名: ABC27; ABC50应用: IHC反应种属: Human, Mouse, Rat
-
分类: 科研抗体货号: P07746别名:应用: WB,IHC反应种属: Human, Mouse, Rat
-
分类: 科研抗体货号: P07715别名: PCI; PAI3; PAI-3; PCI-B; PROCI; PLANH3应用: WB,IHC反应种属: Human
-
分类: 科研抗体货号: P07731别名: EST201864应用: IHC反应种属: Human, Mouse, Rat
-
分类: 科研抗体货号: P07745别名: SCAD; ACAD3应用: WB,IHC反应种属: Human, Mouse, Rat
-
分类: 科研抗体货号: P07730别名: ABC28; M-ABC1; HUSSY18; HUSSY-18; EST133090应用: IHC反应种属: Human, Mouse

鄂公网安备42018502007531号
鄂公网安备42018502007531号

